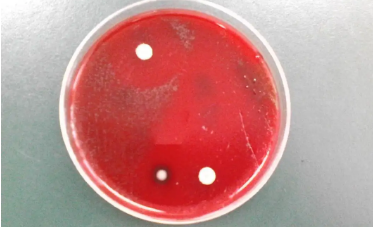

发布旉����Q?022-03-26 来源�Q?a href='http://m.duobaojiqiao.com/news/28.html'>http://m.duobaojiqiao.com/news/28.html
�l�历了百�q�发展的微生物学�Q�目前已�l�渗透到了我们的生活中,比如有医药医学和食品安全�{�比较重要的领域上。随着微生物学研究的深入,已经诞生出MALDI-TOF MS和mNGS全新的方法来帮助大家获得全面的认知。下�?a href="http://m.duobaojiqiao.com/" target="_blank">厌氧工作�?/strong>��׃ؓ(f��)�(zh��n)�介�l�苛养菌�?/span>
然而,培养�Ҏ(gu��)��仍然是一套金标准�Q�微生物的收集、运输、培��d��分离仍然臛_��重要。微生物的培��d��分离在分析和识别中�v着臛_��重要的作用�?/span>
一�p�d��对生长环境和营养要求苛刻的细菌,在普通环境中不能或难以生长,我们�U�C�������养菌。包括专用厌氧菌、兼性厌氧菌、微需氧菌、嗜二氧化碳菌等�?/span>
一�p�d���Ҏ(gu��)��体环境和营养要求较高的微生物。包括厌氧菌、微需氧菌、嗜二氧化碳菌等�?/span>
苛养菌广泛分布在肠道、口腔、眼睛、上呼吸道、泌���K���{�自然界、�h�c�d��动物体内。随着生物��d���{�技术的发展�Q�其中一些已被�h�c�驯化和使用�Q�作为食品中的有益细菌,或作�����物蝲体进入�h体;另一部分明显有害�Q�或影响��Z��健康或��品质量;另一部分仍不清楚�Q�需要研�I��h员进一步探索�?/span>
苛养菌这�U�菌�c�M��要分布在自然界里面,比如在动物的体内。不�q�随着微生物研�I�的深入技术的发展�Q�其中已�l�有一部分能够被��用,而其他不明确的部分还需要���l�研�I�探索。相信在未来世界�?a href="http://m.duobaojiqiao.com/" target="_blank">厌氧工作�?/strong>�?x��)有更深入的发现�Q��?zh��n)�觉得呢�?/span>